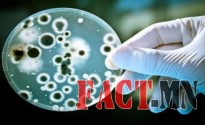
527-1464309997антибиотик1

Дур мэдэн антибиотик хэрэглэхээс татгалзаарай
Томуу, томуу төст өвчин нь вирусээр үүсгэгддэг амьсгалын цочмог халдварт өвчин юм. Амьсгалын замын цочмог халдварт өвчин нь халуурах, толгой өвдөх, ханиалгах, хамраас нус гоожих, үе мөч, булчингаар өвдөх буюу ерөнхий хордлогын шинжээр илэрдэг. Энэ өвчнөөс хэрхэн урьдчилан сэргийлэх, эмнэлгийн тусламж үйлчилгээг ямар үед авах, эмчилгээний аль төрлийг сонгох боломжтой талаар Нийслэлийн Эрүүл мэндийн газраас уг зөвлөмжийг олон нийтэд хүргэж байна.
Томуу, томуу төст өвчнөөс хэрхэн сэргийлэх вэ?
- Өвчлөлөөс сэргийлэх хамгийн сайн хамгаалалт нь биеийн эсэргүүцэл сайтай байх тул витамин ихтэй, чанарлаг хоол хүнс хэрэглэх. Биеийн тамирын дасгал хөдөлгөөнийг эрхэмлэн, ажил амралтаа зохицуулж хангалттай унтаж амрах.
- Улирлын байдалд тохируулан хувцаслах. Өвлийн хүйтэнд дулаан малгай, ороолт, бээлий хэрэглэх.
- Шаардлагагүй тохиолдолд олон нийтийн газраар явахгүй байх.
- Хамрын салстыг хамгаалах зорилгоор сонгино, сармисны тосон ханд, оксолины тос түрхэх.
- Гичтэй бүлээн усанд хөлөө 5-10 минут дүрж, хөлийн уланд тосон иллэг хийх.
- Витамин С-ээр элбэг жимс болон шүүс, витамин С-г хэрэглэх.
- Өдөрт 2-3 хумс сармисыг хоол ундандаа тогтмол хэрэглэх.
- Томуу, томуу төст өвчнөөс сэргийлэх цэгчилсэн иллэг хийх.
- Царван, морин шарилжны ханд, содтой болон давстай ус, тамидин зэрэг уусмалаар хоолойгоо тогтмол зайлж хэвших.
- Гэр, сургууль, цэцэрлэг, ажлын байрандаа цэвэр агаар оруулж, өдөрт чийгтэй цэвэрлэгээг 2-оос доошгүй удаа хийх гэх мэт.
Эдгээр аргуудыг хэрэглэхээс гадна томуу, томуу төст өвчнөөс сэргийлэх үндсэн гол арга нь томуугийн эсрэг сайн дурын дархлаажуулалтанд хамрагдах явдал юм. Ялангуяа 2-15 хүртэлх насны хүүхэд, өндөр настан, уушгины архаг суурь өвчтэй хүмүүс хамрагдвал илүү ач холбогдолтой.
Томуу, томуу төст өвчний шинж тэмдэг илэрвэл яах вэ?
- Эмчид яаралтай хандаж, заавар зөвлөгөөг нь сайтар баримтлан дэглэм сахих. Хамт олон, найз нөхөддөө халдвар тараахгүйн тулд эмчийн зааврын дагуу гэртээ эмчлүүлээрэй.
- Халуун аарц, чацарганы шүүс, сармистай хар шөл зэрэг илчлэг сайтай шингэн зүйл ихээр хэрэглэх.
- Амны хаалт байнга зүүж хэвших.
- Гараа сайтар савандаж угааж хэвших. Хүүхдийн тоглоом, аяга, халбага болон шүдний сойзыг өдөр бүр содын уусмалаар ариутгах.
- Үзвэр үйлчилгээ, олон нийтийн газарт сэлгүүцэхгүй байх.
- Томуу, томуу төст өвчний үед аливаа эмийг эмчийн бичиж өгсөн зааврын дагуу зөв зохистой хэрэглэх. Дур мэдэн антибиотик хэрэглэхээс зайлсхийх.
- Томуу төст өвчний үед халуун бууруулах, ханиалга намдаах, амьсгалын замыг чөлөөлөх, хордлого тайлах шингэн хэрэглэх, ардын уламжлалт тан ууж болно.
URL: